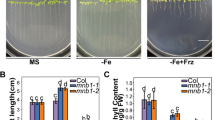

Abstract
Iron (Fe) is an essential element for almost all living organisms. In plants, it is a key player in electron transport in both photosynthesis and respiration. Rice (Oryza sativa L.) is a crop that feeds half of the world’s population. However, rice grains have low Fe concentrations, making populations that base their diet on this crop prone to Fe deficiency. Nutritional Fe deficiency can be addressed by biofortification. To achieve this goal, however, it is necessary to understand plants’ Fe homeostasis mechanisms. Here we evaluate the physiological consequences of loss of OsYSL13 gene in Fe homeostasis and possible alterations in manganese (Mn) homeostasis. We found that leaves of osysl13 mutant plants have lower concentrations of Fe and Mn when extra Mn is added to the soil, compared to wild-type (WT) plants. Mutant osysl13 plants less compared to WT not only in control, but also under Mn deficiency, with decreased shoot biomass accumulation and root length, as well as increased root diameter, suggesting that OsYSL13 has a function in Mn homeostasis. Interestingly, we observed that osysl13 mutant plants accumulate higher H2O2 levels in their leaves, causing visible damages. Mn concentration was also higher in osysl13 leaves compared to WT. Our data suggest that OsYSL13 might be relevant in Mn homeostasis, especially in older leaves facing excessive Mn detoxification,
Similar content being viewed by others
Explore related subjects
Discover the latest articles, news and stories from top researchers in related subjects.Avoid common mistakes on your manuscript.
1 Introduction
Iron (Fe) is indispensable for virtually all living organisms, as it is a cofactor of enzymes and proteins involved in electron transfer in critical biochemical processes, such as respiration and photosynthesis (Gozzelino and Arosio 2016; Kroh and Pilon 2020). In mammals, including humans, Fe is present in the structure of several proteins, such as hemoglobin and myoglobin, both required for oxygen transport and storage in blood and muscle tissues (Gozzelino and Arosio 2016). Because of that, lack of Fe in the diet is a problem and is among the most common nutritional deficiencies in humans, affecting estimated two billion individuals across the globe (Pasricha et al. 2021).
Fe is crucial for photosynthesis and respiration in plants, as it is a component of nonheme Fe proteins and cytochromes and is also required for nitrogen fixation by symbiotic bacteria (Brear et al. 2013; López-Millán et al. 2016). Despite being the most abundant micronutrient in the lithosphere, Fe is not promptly available to plants because it is found in aerobic soils predominantly as Fe(III) (ferric ion, Fe3+), mostly as oxides and hydroxides with low solubility (Poschenrieder et al. 2019). On the other hand, in paddy fields, where rice is commonly cultivated, continuous flooding of the soil causes the reduction of Fe(III) to Fe(II) (ferrous ion, Fe2+), turning the predominant form of Fe in anaerobic soils (Siam et al. 2019).
In plants, two Fe uptake mechanisms are known, named as strategies I and II. Strategy I consists of Fe(III) reduction to Fe(II) and its absorption via the IRT1 transporter (Eide et al. 1996; Korshunova et al. 1999; Vert et al. 2002). On the other hand, Strategy II, performed exclusively by grasses, is based on the secretion of phytosiderophore (PS) compounds that chelate various metal cations, forming complexes (Grillet and Schmidt 2019). These complexes are transported into root cells by the YS1 transporter in maize (Zea mays) and YSL15 in rice (von Wiren et al. 1994; Roberts et al. 2004; Schaaf et al. 2004; Inoue et al. 2009; Lee et al. 2009). The cultivated asian rice (Oryza sativa L.), however, uses a combined strategy consisting of a complete Strategy II and an IRT1-like gene that is upregulated under Fe deficiency. This trait is shared by its closely related species within the Oryza genus (Wairich et al. 2019).
The Yellow Stripe-Like (YSL) family consists of 18 genes in the rice genome. Besides OsYSL15 and its role in Fe(III)-PS uptake, a number of them are linked to Fe, Mn, and Cu long-distance transport chelated to 2’-deoxymugineic acid (DMA) or nicotianamine (NA) (Gross et al. 2003; Koike et al. 2004; Curie et al. 2009; Nozoye et al. 2011; Araki et al. 2015). For example, OsYSL2 is an Fe(II)-NA and Mn(II)-NA transporter relevant for Fe and Mn phloem loading (Koike et al. 2004; Ishimaru et al. 2010; Wang et al. 2013). OsYSL18 is likely involved in the transport of Fe(III)-DMA throughout the plant, including to reproductive organs (Aoyama et al. 2009). OsYSL6 plays a role in Mn(II)-NA transport as a detoxification pathway in Mn excess condition (Sasaki et al. 2011). OsYSL16 transports Fe(III)-DMA in the plant and was shown to participate in Cu-NA transport to young tissues and developing seeds, besides Cu distribution to floral organs (Kakei et al. 2012; Zheng et al. 2012; Zhang et al. 2018a). OsYSL9 is likely involved in the uptake and transport of both Fe(II)-NA and Fe(III)-DMA to developing seeds (Senoura et al. 2017).
OsYSL13 was recently linked to Fe homeostasis (Zhang et al. 2018b). The OsYSL13 gene is predominantly expressed in leaves, especially older ones, and its expression is induced by Fe deficiency. The OsYSL13 protein is found in the plasma membrane. Mutant plants (osysl13) have decreased Fe concentration in young leaves, but higher concentration in mature leaves suggests a role in Fe movement from mature to young leaves. Decreased Fe concentrations are also observed in brown rice. Interestingly, new leaves from osysl13 mutants show less chlorosis than leaves from wild-type plants. The data support the hypothesis that OsYSL13 is involved in Fe distribution from older to younger leaves (Zhang et al. 2018b). However, no link to Mn homeostasis was investigated in this report.
In this study, we further analyzed the function of OsYSL13 by performing physiological and biochemical analyses of osysl13 mutant plants exposed to Fe deficiency and varying Mn concentrations. Besides being involved with Fe homeostasis, our data point to a possible role for OsYSL13 in Mn homeostasis, and suggest that OsYSL13 loss-of-function disturbs Mn concentration in rice plants.
2 Material and methods
2.1 Plant material and growth conditions
The mutant used in this work was obtained from the Rice Mutant Database (RMD; Zhang 2006). The mutants were generated using Agrobacterium tumefaciens transformation of rice (Oryza sativa) cultivar Zhonghua 11 (ZH11), generating T-DNA insertions in multiple regenerated plants. The same mutant line used here (RMD_04Z11MA04; hereafter osysl13) was partially characterized in previous work (Zhang et al. 2018b). As reported by Zhang et al. (2018b), the T-DNA insertion is located in the first exon of OsYSL13 and results in loss-of-function.
For soil experiments, seeds of the Zhonghua 11 (ZH11) cultivar (wild-type; WT) and OsYSL13 knockout mutant line (osysl13) were germinated in Petri dishes soaked in distilled water at 28 ˚C (two days in the dark, two days in 12h/12h light/dark). After germination, seedlings were placed in containers with peat soil and irrigated with standard nutrient solution containing (in µM): 0.01 (NH4)6Mo7O24, 0.2 CuSO4, 0.5 MnSO4, 0.5 ZnSO4, 10 H3BO3, 100 Fe3+-EDTA, 100 KCl, 100 KH2PO4, 500 MgSO4, 700 K2SO4 and 2,000 Ca(NO3)2 (Ricachenevsky et al. 2011). The pH of the nutrient solution was adjusted to 5.4. After 30 days, Mn excess (+ Mn; 50 µM), Zn excess (+ Zn; 200 µM), and Fe excess (+ Fe; 2,230 µM) treatments were applied. Fifteen days later, plants with five leaves had their third fully expanded leaf (n = 6 per treatment) collected for leaf ionomic profiling by inductively-coupled plasma mass spectrometry (ICP-MS). This experimental setup was prepared as a screening for multiple insertion lines for several transporters and metal homeostasis-related proteins (Ricachenevsky et al., unpublished). We only show here the data for the ZH11 wild-type and osysl13 plants. The concentrations and exposure times were used because these factors may disturb the ionome, though symptoms are not visually toxic to the plants.
For hydroponics, seeds of the WT and osysl13 were disinfected and placed in a vessel containing distilled water for 24 h in the dark at 25 °C. Then, seeds were placed in Petri dishes soaked in distilled water for 7 days, under a photoperiod of 16 h/8 h light/dark at 25 °C. After germination, seedlings were transferred to 50 mL pots filled with vermiculite for 2 weeks and irrigated with standard nutrient solution every 3 days (as described above). Plants were transferred to 400 mL pots containing nutrient solution and each pot containing six plants was considered as an experimental unit. Following 2 weeks of acclimation, between the third and fourth leaf stages, Fe deficiency (−Fe), Mn deficiency (−Mn), and Mn excess (1000 µM; +Mn) treatments were applied for 5 weeks, besides the control condition (CC). The nutrient solution was changed every 3 days. ICP-MS was performed in the second fully expanded leaf.
2.2 Element quantification of plant samples
For element quantification from soil-grown plants, leaf samples (n = 5) were collected from mutant and WT plants, dried at 80 ºC, and mineralized. Analysis was performed as described previously by Ricachenevsky et al. (2018) and Pita-Barbosa and Ricachenevsky (2022). For the analysis of hydroponics-grown plants, weighted samples were mineralized with 500 µL concentrated nitric acid (Merck, 65%) for two hours, irradiating in a microwave oven for 30 min at 60% power, in cycles of 20 s irradiation on/20 s off. After cooling, samples were diluted in purified water (18.2 MΩ cm). Phosphorus was determined by ICP-OES (Spectro Ciros CCD, Spectro Analytical Instruments, Germany), while other elements were determined by ICP-MS (Elan DRC II, Perkin Elmer Sciex, Canada) by using similar conditions as described previously (Gindri et al. 2020; Navarro et al. 2021). For analyses by ICP-MS and ICP-OES, sample solutions were diluted 50, 100, or 200-fold when necessary.
2.2.1 Shoot height and dry mass of shoots and roots
Shoot height was determined using a graduated ruler, measuring from the base of the culm to the leaf tip (n = 8). Shoots and roots were collected and dried in a forced ventilation oven at 65 °C until constant mass. The dry mass values were obtained using an analytical precision balance (n = 8).
2.2.2 Quantification of photosynthetic pigments
Chlorophyll and carotenoid concentrations were determined according to Hiscox and Israelstam (1979) and estimated by equations of Lichtenthaler (1987). Leaves (approximately 50 mg) were powdered and frozen (−80 °C). Then, samples were incubated at 65 °C in dimelthylsulfoxide (DMSO) until pigments were completely removed. The absorbances at 470, 645, and 663 nm wavelengths were used to determine the concentration of carotenoids, chlorophyll a, and chlorophyll b, respectively. The total chlorophyll concentration corresponds to the sum of chlorophyll a and chlorophyll b (Hiscox and Israelstam 1979).
2.3 Root measurements
Eight to 12 plants per treatment were used for root biometric evaluations. Root length (cm plant-1), surface area (cm2 plant-1), mean diameter (mm plant-1), and volume (cm3 plant-1) were evaluated. A photo scanner (Epson Expression 11000XL-PH, USA) was used to digitalize the root images at 600 dpi resolution. WinRHIZO© Pro 2007 software was used to analyze images.
2.3.1 Hydrogen peroxide quantification
The concentration of hydrogen peroxide (H2O2) was determined according to Loreto and Velikova (2001). Leaf samples (approximately 100 mg) were mixed in 1.5 mL of 0.1% (w/v) trichloroacetic acid (TCA). The content was homogenized and then centrifuged at 12,000 g for 15 min at 4 °C. 0.5 mL of the supernatant was added to 0.5 mL of 10 mM potassium phosphate buffer (pH 7.0) and 1 mL of 1 M potassium iodide (KI). The H2O2 concentration, expressed as nmol g FW-1, was determined in a spectrophotometer at 390 nm using a standard calibration curve.
2.4 Data analysis
Mean values were statistically compared by the Student’s t-test or by Two-Way ANOVA and Tukey’s post-hoc test (P-value ≤ 0.05, 0.01, 0.001, and 0.0001), using the GraphPad Prism 9 (GraphPad Software) for Windows.
3 Results
3.1 OsYSL13 loss-of-function affects both Fe and Mn homeostasis
Wild-type and osysl13 plants were cultivated in soil irrigated with control nutrient solution or increased Fe, Mn, or Zn concentrations. Young leaves from osysl13 mutant plants had lower Fe concentrations in control (−25%), +Fe (−21%), +Mn (−32%), and + Zn excess (−26%) conditions when compared to WT plants (Fig. 1A). Leaf Mn concentration was 36, 29 and 53% lower in control, +Fe excess and +Mn excess conditions, respectively, in the osysl13 mutant plants compared to WT (Fig. 1B). The leaf Zn concentration was similar in osysl13 and WT plants in all tested conditions (Fig. 1C). These results indicate that osysl13 young leaves have decreased Fe concentration in all tested conditions, which partially agrees with previous data (Zhang et al. 2018b). Our data shows that Mn concentration is disturbed, suggesting that OsYSL13 loss-of-function affects Mn homeostasis directly or indirectly.
Fe, Mn, and Zn concentrations on the third fully expanded leaf from wild-type (WT) and osysl13 mutant soil-grown rice plants under control (CC), Fe-excess (2,230 µM; +Fe), Mn-excess (50 µM; +Mn), or Zn-excess (200 µM; +Zn) conditions for 15 days. A Leaf Fe concentrations. B Leaf Mn concentrations. C Leaf Zn concentrations. Error bars indicate SE. Statistically significant differences between WT and osysl13 plants were determined by Student’s t-test (* P ≤ 0.05; ** P ≤ 0.01; *** P ≤ 0.001). Each black dot represents an individual measurement. DM, dry mass
We found increases in P concentrations in leaves of the osysl13 mutant when compared to WT leaves: +38% in control condition, + 15% in + Fe, + 71% in + Mn, and + 75% in + Zn (Table S1). Concentrations of Ca and Sr, two chemical analogs, were both reduced in all tested conditions, with concentrations in osysl13 reaching 60–75% of those found in WT plants. Similarly, concentrations of Mo were lower in all conditions (50–77%), as well as S (74–82%, except in the + Zn treatment, where similar S concentrations were observed in osysl13 and WT plants; Table S1). These results suggest an indirect effect of the OsYSL13 loss-of-function in the leaf ionome.
3.2 OsYSL13 loss-of-function is detrimental to shoot and root growth
Since we observed consistent changes in Fe and Mn concentrations in leaves of osysl13 plants, and different YSL transporters are known to are known to transport both Fe and Mn, we sought to evaluate these plants in long-term experiments under control, Fe deficiency (−Fe), Mn deficiency (−Mn), and Mn excess (+Mn) conditions (Fig. 2A). When compared to WT, shoot height of osysl13 mutant plants was lower in control (−26%), −Fe deficiency (−13%), −Mn deficiency (−22%), and −Mn excess −11%) conditions (Fig. 2B). Shoot dry mass was also lower in osysl13 mutant plants in control (−20%) and −Mn deficiency (−21%) conditions, while it was slightly higher under +Mn excess condition (+ 25%) (Fig. 2C). Surprisingly, no significant changes were observed in root dry mass between the two genotypes in all tested conditions (Fig. 2D). We scanned the roots to evaluate the effects of OsYSL13 loss-of-function in root architecture. Compared to WT, root length of osysl13 mutant plants was lower (23% and 25% under control and −Mn deficiency conditions, respectively—Fig. 3A). Besides, lower root surface area (19 and 24% under control and −Fe deficiency conditions, respectively—Fig. 3B), and lower root volume (23% under −Fe deficiency condition—Fig. 3D) were observed. Interestingly, the mean diameter in osysl13 roots was 15% and 10% higher under −Mn deficiency and +Mn excess, respectively, when compared to WT roots (Fig. 3C). The root volume in mutant osysl13 plants was lower than in WT plants only under the −Fe treatment (Fig. 3D).
3.3 OsYSL13 loss-of-function decreases chlorophyll concentration
Under control and −Fe deficiency conditions, osysl13 mutant plants presented lower concentrations of chlorophyll a (16.5 and 33%, respectively—Fig. 4A), chlorophyll b (36 and 48%, respectively—Fig. 4B), and total chlorophyll (a + b) concentrations (21% and 35%, respectively—Fig. 4C) than WT plants. No significant differences in carotenoid concentrations were observed between the two genotypes in any tested conditions (Fig. 4D).
Shoot height and dry mass of shoots and roots (n = 15 to 20) from wild-type (WT) and osysl13 mutant rice plants under control (CC), Fe deficiency (–Fe), Mn-deficiency (–Mn), or Mn-excess (1,000 µM; +Mn) treatments for 5 weeks. A Representative images of plants after 5 weeks of treatment. B Shoot height. C Shoot dry mass. D Root dry mass. Error bars indicate SE. Statistically significant differences between WT and osysl13 plants were determined by Student’s t-test (* P ≤ 0.05; ** P ≤ 0.01; **** P ≤ 0.0001). Each black dot represents an individual measurement
3.4 osysl13 mutant plants accumulate more hydrogen peroxide than WT
To check if the lack of a functional OsYSL13 gene could generate a stressful response in osysl13 plants, we quantified hydrogen peroxide (H2O2) concentrations in leaves from mutant and WT plants. When compared to WT, osysl13 plants presented higher concentrations of H2O2 under control (12%), −Fe deficiency (42%), and +Mn excess (27%) conditions (Fig. 5A). Notably, the fourth leaf was clearly senescent in osysl13 plants treated with +Mn excess, while WT plants presented lower senescence levels (Fig. 5B). Therefore, osysl13 plants accumulate more H2O2 than WT and are differentially affected by +Mn excess.
Biometric evaluations of roots (n = 8 to 12) from wild-type (WT) and osysl13 mutant rice plants exposed to control (CC), Fe-deficiency (–Fe), Mn-deficiency (–Mn), or Mn-excess (1000 µM; +Mn) treatments for 5 weeks. A Root length. B Root surface area. C Mean root diameter. D Root volume. Error bars indicate SE. Statistically significant differences between WT and osysl13 plants were determined by Student’s t-test (* P ≤ 0.05; ** P ≤ 0.01; **** P ≤ 0.0001). Each black dot represents an individual measurement
3.5 Changes in the ionome of osysl13 plants under Mn excess suggest an indirect effect of osYSL13 loss-of-function
Ionomic profiling was performed in older leaves (second fully expanded) from WT and osysl13 plants grown in hydroponic system (Fig. 6). While Fe concentration in leaves of WT plants was lower in −Fe deficiency compared to control condition, similar −Fe concentrations were observed in osysl13 plants regardless of the tested condition (Fig. 6A). Interestingly, we observed that Mn concentrations were similar in WT and osysl13 plants under control, −Fe and –Mn conditions (Fig. 6B). However, while both genotypes increased Mn concentration under + Mn, it was clear that osysl13 plants presented higher Mn concentration compared to WT (Fig. 6B). Zn concentrations did not change (Fig. 6C).
Concentration of photosynthetic pigments (n = 3) in leaves wild-type (WT) and osysl13 mutant rice plants under control (CC), Fe-deficiency (Fe−), Mn-deficiency (Mn−), or Mn-excess (1000 µM; Mn+) condition for 5 weeks. A Chlorophyll a concentration. B Chlorophyll b concentration. C Total chlorophyll (a + b) concentration. D Carotenoids concentration. Error bars indicate SE. Statistically significant differences between WT and osysl13 plants were determined by Student’s t-test (*P ≤ 0.05; ** P ≤ 0.01). Each black dot represents an individual measurement. DM, dry mass
Changes in other elements were also observed (Fig. 4D–I). P concentrations were higher in osysl13 than in WT leaves under −Fe deficiency (Fig. 6D). No clear differences were observed for Cd (Fig. 6E), whereas Co accumulated less in osysl13 leaves exposed to excess +Mn (Fig. 6F). Cu accumulated less in osysl13 leaves compared to WT in control condition (Fig. 6G), while both Ni and Se showed no differences (Fig. 6H and I). Therefore, the data suggest that OsYSL13 has an indirect role in regulating the ionome in rice leaves, and that the +Mn phenotype (Fig. 5B) could be related to increased Mn concentration in older leaves, (Fig. 6B).
4 Discussion
Proteins from the YSL family transport metal-DMA/NA complexes. OsYSL2 uses both Fe and Mn as substrates, while OsYSL6 and OsYSL9/OsYSL18 are specific to Mn or Fe, respectively (Aoyama et al. 2009; Ishimaru et al. 2010; Sasaki et al. 2011; Senoura et al. 2017). Previously, OsYSL13 was described as a plasma membrane transporter involved in Fe distribution from older to younger leaves (Zhang et al. 2018b). However, no data about the substrate of OsYSL13 is available, raising the question of whether OsYSL13 could transport both Fe and Mn. Our study supports the previous hypothesis that OsYSL13 is involved in Fe homeostasis (Zhang et al. 2018b), likely with a role in Fe remobilization, and further suggests that it may also have a role in Mn homeostasis. We found that OsYSL13 loss-of-function leads to decreased Fe concentrations in young leaves of soil-growing rice plants in different conditions (Fig. 1A). This is consistent with previous observations for the same mutant line (Zhang et al. 2018b). We also observed that mature leaves do not show the same change (Fig. 6A). While Zhang et al. (2018b) found that mature leaves have increased Fe concentration, we found no statistical difference comparing osysl13 and WT (Fig. 6A). Such difference could be due to distinct experimental conditions and/or plant age used in each experiment, as already observed for other transporters (Tan et al. 2019; Gindri et al. 2020).
We also observed that young leaves of osysl13 plants present a more pronounced decrease in both a and b chlorophyll concentrations when exposed to −Fe deficiency, when compared to WT leaves (Fig. 4A–C), which agrees with a lower −Fe concentration (Zhang et al. 2018b). Growth is also affected in osysl13 since mutant plants present lower shoot height in control, −Fe deficiency, −Mn deficiency, and +Mn excess conditions, as well as changes in root architecture (Figs. 2 and 3). Therefore, loss of OsYSL13 function seems to affect the normal growth of rice plants, which was not which was not detected in previous studies. The fact that osysl13 mutants are smaller than WT plants under control condition suggests that a functional OsYSL13 protein is important even when Fe/Mn are not deficient/excessive in the growth media. Overall, our data support the previously proposed role of OsYSL13 in Fe remobilization from mature to young leaves (Zhang et al. 2018b).
A Hydrogen peroxide (H2O2) concentration (n = 3) in leaves of wild-type (WT) and osysl13 mutant rice plants under control (CC), Fe-deficiency (Fe−), Mn-deficiency (Mn−), or Mn-excess (1000 µM; Mn+) treatments for 5 weeks. B Phenotype of the fourth leaf from WT and osysl13 mutant plants under control (CC) or Mn-excess (Mn+) conditions for 5 weeks. Error bars indicate SE. Statistically significant differences between WT and osysl13 plants were determined by Student’s t-test (*P ≤ 0.05; **** P ≤ 0.0001). Each black dot represents an individual measurement. FM, fresh mass
Elemental profiling of the second fully expanded leaf of wild-type (WT) and osysl13 mutant rice plants grown in nutrient solutions under control (CC), Fe deficiency (−Fe), Mn deficiency (−Mn), or Mn excess (1000 µM Mn) treatments for 5 weeks. A Leaf Fe concentrations. B Leaf Mn concentrations. C Leaf Zn concentrations. D Leaf P concentrations. E Leaf Cd concentrations. F Leaf Co concentrations. G Leaf Cu concentrations. H Leaf Ni concentrations. I Leaf Se concentrations. Error bars indicate SE. Statistically significant differences within each genotype compared to the control condition or between the two genotypes in the same treatment were determined by Two-Way ANOVA and Tukey’s post-hoc test (* P ≤ 0.05; ** P ≤ 0.01; **** P ≤ 0.0001). Each black dot represents an individual measurement. DM, dry mass
The ionome is integrated, and crosstalk between homeostasis of different elements was already described (Pita-Barbosa et al. 2019). In the previous description of the osysl13 mutant line used in this study, Zhang et al. (2018b) did not analyze the possible role of OsYSL13 in Mn homeostasis. We found that Mn concentration is decreased in young leaves of soil-cultivated osysl13 plants (Fig. 1B). Such effect is more pronounced under the +Mn excess treatment, in which lower Mn concentrations were observed in osysl13 mutants than in WT plants (Fig. 1B), suggesting that OsYSL13 might be involved in delivering Mn to young leaves. It is noteworthy that the high Mn condition used in soil experiments (+ 50 µM Mn) is not toxic to rice plants, as no symptoms of Mn toxicity were observed. On the other hand, the excess Mn condition (1000 µM Mn) used in the hydroponic system is toxic to rice, as shown by the appearance of expected symptoms in WT plants (Fig. 5; Sasaki et al. 2011; Chen et al. 2013; Takemoto et al. 2017). Interestingly, osysl13 plants were more damaged by Mn toxicity compared to WT. Such response is similar to that seen in osysl6 mutant plants exposed to excessive Mn, although less pronounced (Fig. 5; Sasaki et al. 2011). As osysl6 plants were more sensitive to Mn toxicity, it was hypothesized that OsYSL6 was involved in Mn detoxification in rice. While no change in total leaf Mn concentration was observed in osysl6 plants, a higher and lower Mn concentration was detected, respectively, in the apoplast and symplast of mature leaves compared to WT plants (Sasaki et al. 2011). We observed that mature leaves, which exhibit more pronounced Mn toxicity symptoms, exhibit higher Mn concentration (Fig. 6B), suggesting that OsYSL13 might be important for Mn detoxification present high Mn conditions. Corroborating this hypothesis, hypothesis, we found higher concentration of H2O2 in shoots of osysl13 than in WT plants. Such effect was detected in the control treatment, but it was more pronounced under −Fe deficiency and +Mn excess conditions (Fig. 5). The data indicate that osysl13 plants are more sensitive to Mn excess, which could be due to OsYSL13 role in +Mn detoxification. However, more experiments are needed to test this hypothesis.
5 Conclusion
Here we provide evidence that supports the previously proposed role of OsYSL13 in Fe remobilization from mature to young leaves. We propose that OsYSL13 loss-of-function mutation changes the leaf ionome (beyond Fe concentration) and that variation in Mn concentration in the growth media leads to growth changes in osysl13 plants. We observed that Mn excess leads to more pronounced Mn toxicity symptoms in osysl13 than in WT plants, as well as increased Mn concentration in older leaves. Altogether, our work suggests that OsYSL13 might have a role in regulating Mn homeostasis.
References
Aoyama T, Kobayashi T, Takahashi M et al (2009) OsYSL18 is a rice iron(III)–deoxymugineic acid transporter specifically expressed in reproductive organs and phloem of lamina joints. Plant Mol Biol 70:681–692. https://doi.org/10.1007/s11103-009-9500-3
Araki R, Namba K, Murata Y, Murata J (2015) Phytosiderophores revisited: 2′-deoxymugineic acid-mediated iron uptake triggers nitrogen assimilation in rice (Oryza sativa L.) seedlings. Plant Signal Behav 10:e1031940. https://doi.org/10.1080/15592324.2015.1031940
Brear EM, Day DA, Smith PMC (2013) Iron: an essential micronutrient for the legume-rhizobium symbiosis. Front Plant Sci. https://doi.org/10.3389/fpls.2013.00359
Chen Z, Fujii Y, Yamaji N et al (2013) Mn tolerance in rice is mediated by MTP8.1, a member of the cation diffusion facilitator family. J Exp Bot 64:4375–4387. https://doi.org/10.1093/jxb/ert243
Curie C, Cassin G, Couch D et al (2009) Metal movement within the plant: contribution of nicotianamine and yellow stripe 1-like transporters. Ann Bot 103:1–11. https://doi.org/10.1093/aob/mcn207
Eide D, Broderius M, Fett J, Guerinot M, Lou (1996) A novel iron-regulated metal transporter from plants identified by functional expression in yeast. Proc Natl Acad Sci USA. https://doi.org/10.1073/pnas.93.11.5624
Gindri RG, Navarro BB, da Cruz Dias PV et al (2020) Physiological responses of rice (Oryza sativa L.) oszip7 loss-of-function plants exposed to varying Zn concentrations. Physiol Mol Biol Plants 26:1349–1359. https://doi.org/10.1007/s12298-020-00824-z
Gozzelino R, Arosio P (2016) Iron homeostasis in health and disease. Int. J. Mol. Sci 17:130
Grillet L, Schmidt W (2019) Iron acquisition strategies in land plants: not so different after all. New Phytol. https://doi.org/10.1111/nph.16005
Gross J, Stein RJ, Fett-Neto AG, Fett JP (2003) Iron homeostasis related genes in rice. Genet Mol Biol. https://doi.org/10.1590/S1415-47572003000400012
Hiscox JD, Israelstam GF (1979) A method for the extraction of chlorophyll from leaf tissue without maceration. Can J Bot. https://doi.org/10.1139/b79-163
Inoue H, Kobayashi T, Nozoye T et al (2009) Rice OsYSL15 is an iron-regulated iron (III)-deoxymugineic acid transporter expressed in the roots and is essential for iron uptake in early growth of the seedlings. J Biol Chem 284:3470–3479. https://doi.org/10.1074/jbc.M806042200
Ishimaru Y, Masuda H, Bashir K et al (2010) Rice metal-nicotianamine transporter, OsYSL2, is required for the long-distance transport of iron and manganese. Plant J 62:379–390. https://doi.org/10.1111/j.1365-313X.2010.04158.x
Kakei Y, Ishimaru Y, Kobayashi T et al (2012) OsYSL16 plays a role in the allocation of iron. Plant Mol Biol. https://doi.org/10.1007/s11103-012-9930-1
Koike S, Inoue H, Mizuno D et al (2004) OsYSL2 is a rice metal-nicotianamine transporter that is regulated by iron and expressed in the phloem. Plant J 39:415–424. https://doi.org/10.1111/j.1365-313X.2004.02146.x
Korshunova YO, Eide D, Clark WG et al (1999) The IRT1 protein from Arabidopsis thaliana is a metal transporter with a broad substrate range. Plant Mol Biol 40:37–44. https://doi.org/10.1023/a:1026438615520
Kroh GE, Pilon M (2020) Regulation of iron homeostasis and use in chloroplasts. Int J Mol Sci 21:3395. https://doi.org/10.3390/ijms21093395
Lee S, Chiecko JC, Kim SA et al (2009) Disruption of OsYSL15 leads to iron inefficiency in rice plants. Plant Physiol 150:786–800. https://doi.org/10.1104/pp.109.135418
Lichtenthaler HK (1987) Chlorophylls and carotenoids: pigments of photosynthetic biomembranes. Methods Enzymol. https://doi.org/10.1016/0076-6879(87)48036-1
López-Millán AF, Duy D, Philippar K (2016) Chloroplast iron transport proteins—function and impact on plant physiology. Front Plant Sci. https://doi.org/10.3389/fpls.2016.00178
Loreto F, Velikova V (2001) Isoprene produced by leaves protects the photosynthetic apparatus against ozone damage, quenches ozone products, and reduces lipid peroxidation of cellular membranes. Plant Physiol. https://doi.org/10.1104/pp.010497
Navarro BB, Del Frari BK, da Dias PV C, et al (2021) The copper economy response is partially conserved in rice (Oryza sativa L). Plant Physiol Biochem 158:113–124. https://doi.org/10.1016/j.plaphy.2020.11.051
Nozoye T, Nagasaka S, Kobayashi T et al (2011) Phytosiderophore efflux transporters are crucial for iron acquisition in graminaceous plants. J Biol Chem 286:5446–5454. https://doi.org/10.1074/jbc.M110.180026
Pasricha SR, Tye-Din J, Muckenthaler MU, Swinkels DW (2021) Iron deficiency. Lancet 397:233–248
Pita-Barbosa A, Ricachenevsky FK (2022) Heavy metal ATPase 3 expression controls zinc homeostasis in natural accessions of Arabidopsis thaliana. Theor Exp Plant Physiol 34:509–515. https://doi.org/10.1007/s40626-022-00261-1
Pita-Barbosa A, Ricachenevsky FK, Flis PM (2019) One “OMICS” to integrate them all: ionomics as a result of plant genetics, physiology and evolution. Theor Exp Plant Physiol 31:71–89. https://doi.org/10.1007/s40626-019-00144-y
Poschenrieder C, Busoms S, Barceló J (2019) How plants handle trivalent (+3) elements. Int J Mol Sci 20:3984. https://doi.org/10.3390/ijms20163984
Ricachenevsky FK, de Araújo Junior AT, Fett JP, Sperotto RA (2018) You shall not pass: root vacuoles as a symplastic checkpoint for metal translocation to shoots and possible application to grain nutritional quality. Front Plant Sci. https://doi.org/10.3389/fpls.2018.00412
Roberts LA, Pierson AJ, Panaviene Z, Walker EL (2004) Yellow stripe1. Expanded roles for the maize iron-phytosiderophore transporter. Plant Physiol. https://doi.org/10.1104/pp.103.037572
Sasaki A, Yamaji N, Xia J, Ma JF (2011) OsYSL6 is involved in the detoxification of excess manganese in rice. Plant Physiol 157:1832–1840. https://doi.org/10.1104/pp.111.186031
Schaaf G, Ludewig U, Erenoglu BE et al (2004) ZmYS1 functions as a proton-coupled symporter for phytosiderophore- and nicotianamine-chelated metals. J Biol Chem 279:9091–9096. https://doi.org/10.1074/jbc.M311799200
Senoura T, Sakashita E, Kobayashi T et al (2017) The iron-chelate transporter OsYSL9 plays a role in iron distribution in developing rice grains. Plant Mol Biol 95:375–387. https://doi.org/10.1007/s11103-017-0656-y
Siam HS, Mahmoud SA, Taalab AS, Ageeb GW (2019) A review of electrochemical changes in submerged soils. Plant Arch 19:1965–1973
Takemoto Y, Tsunemitsu Y, Fujii-Kashino M et al (2017) The tonoplast-localized transporter MTP8.2 contributes to manganese detoxification in the shoots and roots of Oryza sativa L. Plant Cell Physiol 58:1573–1582. https://doi.org/10.1093/pcp/pcx082
Tan L, Zhu Y, Fan T et al (2019) OsZIP7 functions in xylem loading in roots and inter-vascular transfer in nodes to deliver Zn/Cd to grain in rice. Biochem Biophys Res Commun 512:112–118. https://doi.org/10.1016/j.bbrc.2019.03.024
Vert G, Grotz N, Dédaldéchamp F et al (2002) IRT1, an Arabidopsis transporter essential for iron uptake from the soil and for plant growth. Plant Cell. https://doi.org/10.1105/tpc.001388
von Wiren N, Mori S, Marschner H, Romheld V (1994) Iron inefficiency in maize mutant ys1 (Zea mays L. cv Yellow-Stripe) is caused by a defect in uptake of iron phytosiderophores. Plant Physiol 106:71–77. https://doi.org/10.1104/pp.106.1.71
Wairich A, de Oliveira BHN, Arend EB et al (2019) The combined strategy for iron uptake is not exclusive to domesticated rice (Oryza sativa). Sci Rep. https://doi.org/10.1038/s41598-019-52502-0
Wang M, Gruissem W, Bhullar NK (2013) Nicotianamine synthase overexpression positively modulates iron homeostasis-related genes in high iron rice. Front Plant Sci 4:156. https://doi.org/10.3389/fpls.2013.00156
Zhang J (2006) RMD: a rice mutant database for functional analysis of the rice genome. Nucleic Acids Res 34:D745–D748. https://doi.org/10.1093/nar/gkj016
Zhang C, Lu W, Yang Y et al (2018) OsYSL16 is required for preferential Cu distribution to floral organs in rice. Plant Cell Physiol 59:2039–2051. https://doi.org/10.1093/pcp/pcy124
Zhang C, Shinwari K, Luo L, Zheng L (2018) OsYSL13 is involved in iron distribution in rice. Int J Mol Sci 19:3537. https://doi.org/10.3390/ijms19113537
Zheng L, Yamaji N, Yokosho K, Ma JF (2012) YSL16 is a phloem-localized transporter of the copper-nicotianamine complex that is responsible for copper distribution in rice. Plant Cell 24:3767–3782. https://doi.org/10.1105/tpc.112.103820
Acknowledgements
The authors thank CNPq (Conselho Nacional de Desenvolvimento Científico e Tecnológico). This study was financed in part by the Coordenação de Aperfeiçoamento de Pessoal de Nível Superior - Brasil (CAPES)—Finance Code 001.
Author information
Authors and Affiliations
Corresponding author
Ethics declarations
Conflict of interest
The authors declare no conflict of interest.
Additional information
Publisher’s Note
Springer Nature remains neutral with regard to jurisdictional claims in published maps and institutional affiliations.
Supplementary Information
Below is the link to the electronic supplementary material.
Rights and permissions
Springer Nature or its licensor (e.g. a society or other partner) holds exclusive rights to this article under a publishing agreement with the author(s) or other rightsholder(s); author self-archiving of the accepted manuscript version of this article is solely governed by the terms of such publishing agreement and applicable law.
About this article
Cite this article
Ponte, L.R., Farias, J.G., Del Frari, B.K. et al. OsYSL13 transporter may play a role in Mn homeostasis in rice (Oryza sativa L.). Theor. Exp. Plant Physiol. 35, 263–274 (2023). https://doi.org/10.1007/s40626-023-00282-4
Received:
Accepted:
Published:
Issue Date:
DOI: https://doi.org/10.1007/s40626-023-00282-4